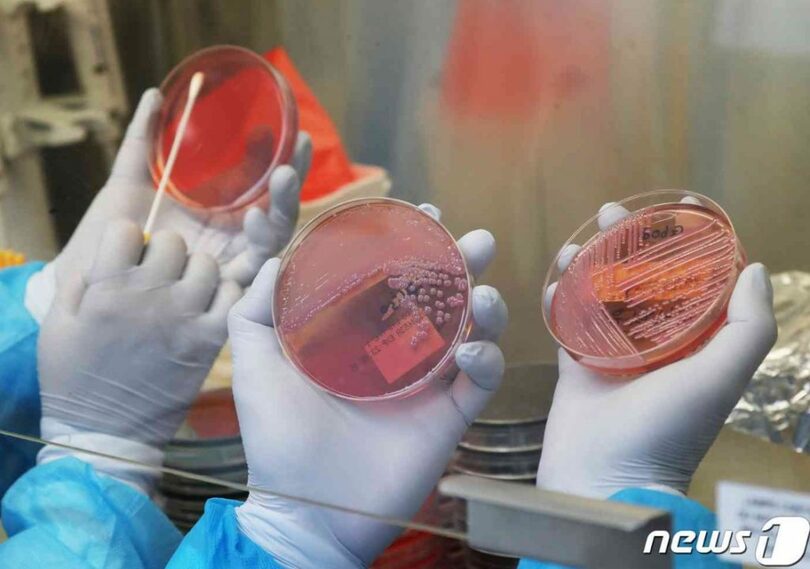
京畿道保健環境研究院で食中毒菌培養検査を実施する職員(c)news1

「下痢して吐いて死ぬかと」…韓国でノロウイルス患者の1カ月間で3倍↑
発信地:韓国
[
韓国・北朝鮮
]
このニュースをシェア
【01月15日 KOREA WAVE】韓国でノロウイルス患者が急増している。疾病管理庁によると、昨年12月24~30日(52週)に腸管感染症の監視事業に参加している206の大規模医療機関から通報があったノロウイルス患者数は268人で、前年同期(178人)の1.5倍に上った。
ノロウイルスの拡散は本格的な冬季に入って始まった。11月26日~12月2日(48週)の患者は91人だったが、1カ月足らずで約3倍の268人に急増した。
腸管感染症の中ではノロウイルスが占める割合が圧倒的。52週の腸管感染症患者327人のうちノロウイルスが82%の268人を占めた。
疾病庁の関係者は「例年に比べて患者数が急速に増えている。ノロウイルスは普通12月から急騰し、1月初めにピークに達するが、増加のスピードがとても速い」と話した。
(c)news1/KOREA WAVE/AFPBB News








